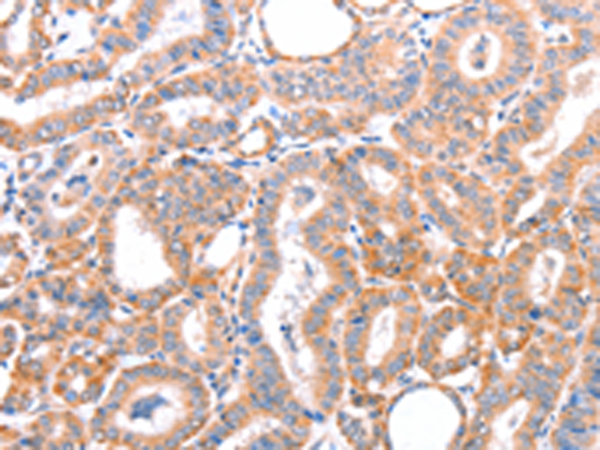
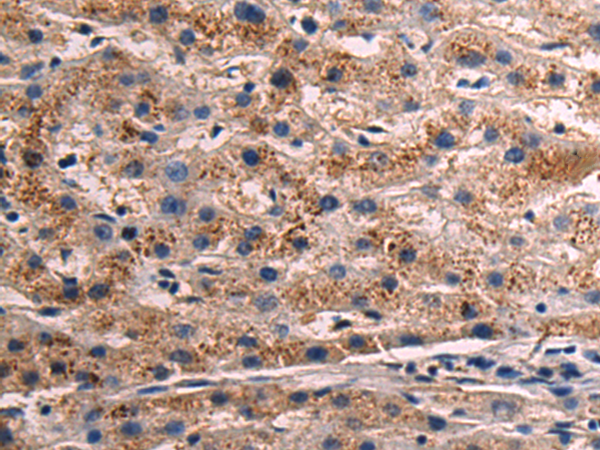
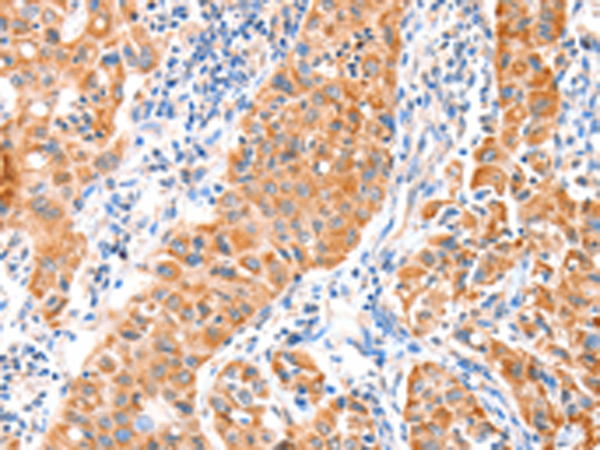

-
分类: 科研抗体货号: P07725别名:应用: IHC反应种属: Human
-
分类: 科研抗体货号: P07724别名: NCEH; AADACL1应用: WB,IHC反应种属: Human, Mouse, Rat
-
分类: 科研抗体货号: P07739别名: ABP; DAO; KAO; ABP1; DAO1应用: IHC反应种属: Human, Mouse, Rat
-
分类: 科研抗体货号: P07723别名: DAC; CES5A1应用: WB,IHC反应种属: Human
-
分类: 科研抗体货号: P07729别名: RLI; OABP; ABC38; RNS4I; RNASEL1; RNASELI应用: WB反应种属: Human, Mouse
-
分类: 科研抗体货号: P07722别名: alpha4GnT应用: IHC反应种属: Human
-
分类: 科研抗体货号: P07738别名: ABLIM; LIMAB1; LIMATIN; abLIM-1应用: WB,IHC反应种属: Human, Mouse
-
分类: 科研抗体货号: P07728别名: ABC; LAN; PRP; umat; MTABC3应用: WB,IHC反应种属: Human, Mouse, Rat
-
分类: 科研抗体货号: P07721别名: LPP2; STB2; STBM2; KITENIN应用: WB,IHC反应种属: Human, Mouse
-
分类: 科研抗体货号: P07737别名: AIP1; ABI-2; ABI2B; AIP-1; AblBP3; argBP1; SSH3BP2; argBPIA; argBPIB应用: IHC反应种属: Human

鄂公网安备42018502007531号
鄂公网安备42018502007531号

